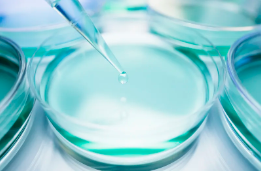
image.png

南通肝硬化幹細胞有什麽作用,流程複雜嗎
2024-11-12 11:43:16 來源: 小編 咨詢醫生
本文将深入探讨幹細胞在肝硬化治療中的作用以及南通地區在這一領域的應用流程,幫助大家更好地了解這一技術。
肝硬化是一種常見的慢性肝病,嚴重時可導緻肝功能衰竭。近年來,幹細胞療法在肝硬化治療領域取得了顯著進展。那麽,南通肝硬化幹細胞療法有什麽作用,流程複雜嗎?下面我們來詳細了解一下。
一、南通肝硬化幹細胞的作用
1.促進肝髒再生:幹細胞具有強大的分化潛能,可以分化爲肝細胞,從而促進肝髒組織的再生,改善肝功能。
2.調節免疫反應:幹細胞具有免疫調節作用,可以減輕肝髒炎症,降低肝硬化患者的病情。
3.改善微環境:幹細胞可以改善肝髒微環境,促進肝細胞的生長和修複,減輕肝纖維化程度。
4.預防并發症:通過幹細胞療法,可以有效降低肝硬化患者并發症的發生率,提高生存質量。
二、南通肝硬化幹細胞治療流程
南通肝硬化幹細胞治療流程主要包括以下幾個步驟:
1.采集和制備幹細胞:首先,醫生會從患者體内采集一定數量的幹細胞,然後進行分離、純化和培養,使其具備足夠的數量和質量。
2.幹細胞移植:将制備好的幹細胞移植到患者體内,移植方式有動脈導管介入、靜脈注射等。
3.康複治療:移植後,患者需要進行一段時間的康複治療,包括抗病毒、保肝、抗纖維化等藥物的治療。
4.随訪和評估:醫生會定期對患者進行随訪,評估治療效果,并根據患者病情調整治療方案。
三、南通肝硬化幹細胞治療的優點
1.安全性高:幹細胞治療無明顯的副作用,對患者的身體健康影響較小。
2.療效顯著:南通肝硬化幹細胞治療在改善肝功能、降低并發症發生率等方面具有顯著療效。
3.無需等待肝源:幹細胞治療不需要等待合适的肝源,避免了肝移植的複雜性和風險。
綜上所述,南通肝硬化幹細胞療法在治療肝硬化方面具有重要作用,流程相對簡單。然而,患者在接受治療前還需充分了解相關信息,選擇正規醫院進行就診,以确保治療安全有效。
-
上一頁: 胚胎幹細胞研究價值如何,有什麽意義
- 2024-11-07中國幹細胞機構有哪些,前10排行榜單最新發布
- 2024-10-26山東幹細胞機構名單:哪家最具實力?
- 2024-09-21體外培養幹細胞技術的優缺點分析
- 2024-08-08幹細胞的用途有哪些,幹細胞的價值和作用
- 2024-11-12幹細胞移植對供者有什麽要求,有多嚴格
- 2024-10-30幹細胞再生最新臨床技術有哪些突破?應用前景如何?
- 2024-09-27廣州貝拉國際醫療細胞治療效果好嗎
- 2024-09-27貝拉細胞醫院怎麽樣
- 2024-09-10幹細胞治療陽痿,重拾男性勃起功能
- 2024-09-16常州人體幹細胞存儲機構,内附細胞儲存費用參考
- 2024-09-21免疫nk幹細胞療法是什麽,你想知道的都在這
- 2024-09-03幹細胞治療帕金森病的價錢和臨床療效
- 2024-10-11幹細胞在未來醫療中有哪些突破性應用?其治療潛力如何體現?
- 2024-09-19幹細胞療法技術原理,幹細胞治療的三大基本原理
- 2024-09-16幹細胞療法的壞處和好處有哪些
- 2024-09-15永康牙髓幹細胞存儲費用是多少
- 2024-10-03提取幹細胞的過程是怎樣的,如何确保提取質量
- 2024-08-14幹細胞療法治療最新成果
